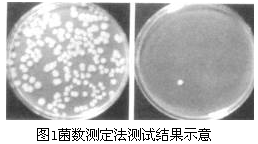
圖片關(guān)鍵詞

版權(quán)所有 2013? http://www.leanlie.cn?網(wǎng)站版權(quán)歸廣州聯(lián)莊科技有限公司所有 ??? 粵ICP備2025496670號-2
資訊中心
聯(lián)系方式
電話:86-20-32058382
傳真:86-20-32057561
手機:13829706661
技術(shù)文章
紡織品抗菌性能測試方法及標準
抗菌紡織品的最重要的性能指標是抗菌性。測試抗菌性時,要求培養(yǎng)基濃度、溫濕度、pH值及試驗時間與穿衣條件相一致,實驗儀器應(yīng)為微生物實驗常用儀器,且對任何形狀的紡織材料都能測試[1]。抗菌性的測試方法中,發(fā)展較早的是日本和美國,最有代表性且應(yīng)用較廣的是美國的AATCC試驗法100和日本的工業(yè)標準。國內(nèi)使用較多的評價方法一般都是參照AATCC(American Association of Textile Chemists and Colorists,美國紡織染色家和化學(xué)家協(xié)會)標準[2]和日本JAFET(日本纖維制品新功能協(xié)議會)批準的"SEK"標志認證標準的方法[3]。我國于1992年頒布了紡織行業(yè)標準FZ/T01021-1992《織物抗菌性能試驗方法》[4],1996年頒布了國家標準GB15979-2002《一次性使用衛(wèi)生用品衛(wèi)生標準》[5]。但是抗菌性能評價的方法和標準還遠末作到系統(tǒng)、統(tǒng)一、規(guī)范,尤其是抗菌紡織品的性能評價和產(chǎn)品規(guī)范在我國還有許多問題不明確,只能做到簡單的定性檢測。
鑒于當前我國對抗菌紡織品的全面評價還不能適應(yīng)國內(nèi)生產(chǎn)和對外貿(mào)易的需要,本文對目前世界上使用較多的抗菌測試方法及標準進行了對比,
1 測試菌種的選擇
微生物(microorganism)是存在于自然界的一群體形細小、結(jié)構(gòu)簡單、肉眼無法直接看到,必須借助顯微鏡等設(shè)備才能觀察到的微小生物。絕大多數(shù)的微生物對人類和動植物是無害的,甚至是有益和必需的。但是也有小部分的微生物可以引起人類和動植物的病害[6]。因而人們在進行抗菌性能的評價中,菌種的選擇必須具有科學(xué)性和代表性。表1列出的菌種是在自然界和人體皮膚及粘膜上分布最為廣泛的。
測試的菌種[7]包括細菌和真菌。在細菌中主要用革蘭氏陽性菌(金黃色葡葡球菌、巨大芽胞桿菌、枯草桿菌)和革蘭氏陰性菌(大腸桿菌、熒光假單胞桿菌);在真菌中主要用霉菌(黑曲霉、黃曲霉、變色曲霉、桔青霉、綠色木霉、球毛殼霉、宛氏擬青霉、臘葉芽枝霉)和癬菌(石膏樣毛癬菌、紅色癬菌、紫色癬菌、鐵銹色小抱子菌、袍子絲菌、白色念珠菌)。
金黃色葡萄球菌是無芽胞細菌中抵抗力最強的致病菌,可作為革蘭氏陽性菌的代表。巨大芽胞桿菌是芽胞類細菌中常見的致病菌;枯草桿菌易形成芽胞,抵抗力強,可作為芽胞菌的代表。大腸桿菌分布相當廣泛,巳作為通常的革蘭氏陰性菌的代表性菌種用于各種試驗。黃曲霉、球毛殼霉作為規(guī)定的防霉試驗用菌種,已列入我國國家標準(GB2423.16-81),其它一些所選擇的霉菌,則是侵蝕紡織品或高分子材料的常見霉菌。白色念珠菌是人體皮膚粘膜常見的條件致病性真菌,對藥物具有敏感性,具真菌的特性,菌落酷似細菌而不是細菌又不同于霉菌,因具有酷似細菌的菌落,易于計數(shù)觀察,常作為真菌的代表。
因此,為考核抗菌紡織品是否具有廣譜抗菌效果,較合理的選擇是按一定的比例,將有代表性的菌種配成混合菌種用于檢測。目前大部分抗菌產(chǎn)品的抗菌性能,往往僅選擇金黃色葡萄球菌、大腸桿菌和白色念珠菌分別作為革蘭氏陽性菌、革蘭氏陰性菌和真菌的代表。但實際上僅用這二種菌來代表織物的抗菌性能是遠遠不夠的。
另外,由于大部分真菌無法計數(shù)菌落數(shù),因此,紡織品抗真菌性能的評價主要通過觀察試樣接觸真菌后,在一定的溫濕度的條件下,經(jīng)過一定時間以后真菌在試樣上的生長情況來評定的,而對真菌生長程度的評定,剛采用英國標準BS6085-81來進行等級評定[8]。
2 紡織品抗菌性能測試方法分類
紡織品抗菌性能的測試分為定量測試方法和定性測試方法,以定量測試方法最為重要。
2·1 定量測試方法
目前紡織品抗菌性能定量測試方法及標準包括美國AATCC Test Method lO0(菌數(shù)測定法)TZ/TO2021-9、奎因(Quinn)實驗法等。
定量測試方法包括織物的消毒、接種測試菌、菌培養(yǎng)、對殘留的菌落計數(shù)等。它適用于非溶出性抗菌整理織物,不適用于溶出性抗菌整理織物,該法的優(yōu)點是定量、準確、客觀,缺點是時間長、費用高。圖1是菌數(shù)測定法測試結(jié)果的例子[9]。
2·2 定性測試方法
定性測試方法主要有美國AATCC Test Method 9O(Halo Test,暈圈法,也叫瓊脂平皿法)、AATCC Test Method 124(平行劃線法)和JISZ2911-1981(抗微生物性實驗法)等。
定性測試方法包括在織物上接種測試菌和用肉眼觀察織物上微生物生長情況。它是基于離開纖維進入培養(yǎng)皿的抗菌劑活性,一般適于溶出性抗菌整理,但不適用于耐洗滌的抗菌整理。優(yōu)點是費用低,速度快,缺點是不能定量測定抗菌活性,結(jié)果不準確。圖2是暈圈法測試結(jié)果的例子[9]。

3 抗菌性能評價方法的選擇
有關(guān)紡織品抗菌性能評價方法的研究,國外已開展了多年,并陸續(xù)建立了一些具有代表性的、相對穩(wěn)定的、可在多個實驗室重復(fù)進行的測定方法。具體見表l和表2。


這些方法中大多數(shù)都存在一定的局限性,各種方法的測定結(jié)果之間沒有嚴格的可比性。而且各自的優(yōu)缺點十分明顯,以下是對幾種常用抗茵測試方法的介紹:
3·l AATCC-90試驗法
又稱暈圈試驗法,是用于抗菌劑篩選的抗菌效力快速定性方法,原理是:在瓊脂培養(yǎng)基上接種試驗菌,再緊貼試樣,于37℃下培養(yǎng)24h后,用放大鏡觀察菌類繁殖情況和試樣周圍無菌區(qū)的暈圈大小,與對照樣的試驗情況比較。此法一次能處理大量的試樣,操作較簡單,時間短。但也存在一些問題,如雖然規(guī)定了在一定時間內(nèi)培養(yǎng)試驗菌液,但是菌濃表l 抗細菌效力測定方法[10]
表2 抗霉菌效力測定方法[10]
卻沒有明確的規(guī)定。另外,阻止帶的寬度代表的是擴散性和抗菌效力,對于與標準織物比較是有意義的,但不能作為抗菌活力的定量評定[11]。
AATCC-90試驗法改良之一(噴霧法)是在培養(yǎng)后的試樣噴灑一定量TNT試劑,肉眼觀察試樣上菌的生長情況。其發(fā)色原理為TNT試劑因試驗菌的琥珀酸脫氫酶的作用被還原,生成不溶紅色色素而顯紅色,從而達到判定抗菌性的目的。該種方法的優(yōu)點就是無論試樣是否有抑菌圈形成,只要平板上有細菌生長,就會顯出紅色[12]。
AATCC-90試驗法改良之二(比色法)是在培養(yǎng)后試樣上的菌洗出液中加入一定量的TNT試劑使發(fā)色,l5min后用分光光度計測定525nm處的吸光度,來求出活菌個數(shù)。但是以上兩方法不適用于無琥珀酸脫氫酶的試驗菌。
3·2 AATCC-l00試驗法
AATCC-l00是一種容量定量分析方法,適用于抗菌紡織品抗菌率的評價。
該法于1961年由AATCC委員會提出,1965,1981,1988,1993年作了修訂。是目前國外使用較廣泛的抗菌性測試法之一。
該法原理為:在待測試樣和對照試樣上接種測試菌,分別加入一定量中和液,強烈振蕩將菌洗出,以稀釋平板法測洗脫液中的菌濃,與對照樣相比計算織物上細菌減少的百分率。此法的缺點是一次試驗的檢體不能太多,且花費時間較長;對于非溶出型試樣,不能進行抗菌性能評價;沒有詳細規(guī)定中和溶液的成份;而且菌液中營養(yǎng)過于豐富,與實際穿著條件相差太大;容器太大,不易操作[13]。
在吸收國內(nèi)外經(jīng)驗的基礎(chǔ)上,經(jīng)過大量的實驗,對其加以改進,形成了一套系統(tǒng)的定量測試方法體系,可以滿足不同抗菌紡織品抗菌性能測試的需要。即改良AATCC-l00,要點如下:
將AATCC-l00法的試樣由直徑為4.8cm的圓形 改為邊長約1.8cm的正方形,將其放入3OmL或50mL帶蓋錐形瓶。用0.85%冰冷生理鹽水(0-4℃)代替AATCC肉湯稀釋接種菌。將菌種從約l08-1O9cfu/mL稀釋到l×lO5-2×lO5cfu/mL,制成接種菌液。用20mL,0.85%冰冷生理鹽水代替中和劑洗滌試樣[14]。
用下式計算試樣的抑菌活性和殺菌活性:
l8h后空白對照樣活菌數(shù)―l8h后試樣活菌數(shù)
抑菌率 = --------------------------------------- ×100%
l8h后空白對照樣活菌數(shù)
‘0’時空白對照樣活菌數(shù)一l8h后試樣活菌數(shù)
殺菌率 = --------------------------------------- ×100%
‘0’時空白對照樣活菌數(shù)
該種方法無論對于溶出型試樣,還是非溶出型試樣,都能進行抗菌測試,而且培養(yǎng)基的養(yǎng)分適合織物的使用條件[12]。
3·3 振蕩瓶法
振蕩瓶法即Shake Flask法,是美國道康寧公司為克服AATCC-l00法的缺點而開發(fā)的可評價非溶出型纖維制品抗菌性能的一種方法。此法為增強試樣與菌的接觸,將樣品投入盛有磷酸鹽緩沖液的有塞三角瓶中,移入菌液后在一定條件下強烈振蕩lh,取lmL試驗液,置于培養(yǎng)基上使細菌繁殖一定時間,檢查菌落數(shù)與空白樣品比較,計算細菌減少率[15]。
該種方法的優(yōu)點是可以適用于大多數(shù)試樣,像粉末狀、有毛或羽的衣服、凸凹不平的織物等都能使用,即使是水溶液中非溶出型的試樣也能評價其抗菌性能[16]。缺點是稀釋液缺少微生物增殖所需用的養(yǎng)分,不符合穿著條件;培養(yǎng)時間短,試驗菌幾乎不能增殖,與日常穿衣時間相差太大;另外振蕩溫度為25℃,并非最佳培養(yǎng)溫度[15]。
振蕩瓶法對親水性的織物測試結(jié)果較準確,雖然也能測試吸水性差的織物,但準確度不是很高。對完全不吸水的纖維,特別是紗線狀物或粉狀、塊狀物品,重現(xiàn)性不太理想,根據(jù)振蕩燒瓶法的優(yōu)點,對其進行改良,要點如下:將菌種從約l08-1O9cfu/mL每次10倍稀釋到1.5×lO5~3.5×lO5cfu/mL,第一次稀釋用AATCC肉湯,第二次開始直到最后一次稀釋用磷酸鹽緩沖液,制成接種菌液。另外,在作10倍系列稀釋時,用0.85%冰冷生理鹽水代替牛肉湯[14]。
3·4 AATCC-30
AATCC-30是對紡織材料抗霉菌和抗腐爛性能的評定。確定了紡織材料抵抗霉菌和耐腐爛的性能,以評定殺菌劑對紡織材料抗菌性能的有效性[18]。分為土埋法、瓊脂平板法及濕度瓶法等兒種方法。 土埋法是指將樣品(具有一定尺寸)埋在泥中一定時間后,測定樣品的斷裂強度。此法是用樣品經(jīng)土埋處理后所損失的斷裂強度來表征其抗霉能力。
瓊脂平板法就是用來評估織物抵抗這類細菌能力的。該法是將含有培養(yǎng)基的瓊脂平板均勻滴上一定量的分散有曲霉菌孢子的水溶液,然后將經(jīng)非離子潤濕劑處理的樣品圓片放置其上,并在樣片上均勻滴加一定量的上述水溶液,在一定的溫度下放置一段時間,最后觀察樣品上霉菌的生長情況。它是用樣品圓片上的霉菌面積來進行表征的。
濕度瓶法是經(jīng)過預(yù)處理的樣品條懸掛置于一個有一定通風的、盛有一定量的分散有一定數(shù)目細菌袍子的水溶液的廣口瓶中,在一定的溫度下放置一段時間。此法也是用樣品條上的霉菌面積進行表征[17]。
3·5 AATCC-147
又稱平行劃線法,是對紡織品抗菌效力的半定量實驗方法,可相對快速和方便地定性測試經(jīng)抗菌整理的紡織材料的抗菌性能,可用來確定具有可擴散抗菌劑的紡織品的抗菌能力。替代了繁瑣的 AATCC-l0O。AATCC-147應(yīng)用于紡織材料的抗菌整理的評定,是對紡織材料抗菌性能的半定量分析[18]。
AATCC-147法是將一定量的培養(yǎng)液(內(nèi)含一定數(shù)目的金黃色葡萄球菌等細菌的抱子)滴加于盛有營養(yǎng)瓊脂平板的培養(yǎng)皿中,使其在瓊脂表面形成五條平行的條紋,然后將樣品垂直放于這些培養(yǎng)液條紋上, 并輕輕擠壓,使其與瓊脂表面緊密接觸,在一定的溫度下放置一定時間。此法是用與樣品接觸的條紋周圍的抑菌區(qū)的寬度來表征織物的抗菌能力[17]。
3·6 J1SZ911抗霉性法
本方法是以試驗菌能分解纖維素作為營養(yǎng)源為前提的。在抗菌防臭加工纖維制品中,對合成纖維進行抗菌試驗時,需要進一步研究能在試驗布上生長的細菌[19]。
4 結(jié)語
從各種資料可以看出,不同單位采用的抗菌紡織品性能評價方法各不相同,抗菌性能表達方式也是多種多樣,不能統(tǒng)一考量。而且每種抗菌性能的測試方法都不是萬能的,都有一定的局限性,因而,應(yīng)形成一套測試方法體系,對不同對象應(yīng)采用不同的測試方法。
5 參考文獻
[1]楊錦釗,抗菌防臭纖維制品的最近動向及課題(上)[J]譯自日本纖維科學(xué),1991,(6):61
[2]楊萍,AATCC紡織品常規(guī)項目檢測方法的新進展[J]印染,2004,(12):32-34
[3]何中琴,纖維制品的抗菌、防臭、消臭加工的基本概念和今后研究開發(fā)的方向[J]印染譯叢,1999,(3):86-93
[4]FZ/T01021-1992織物抗菌性能試驗方法[S]
[5]GB15979-1995一次性使用衛(wèi)生用品衛(wèi)生標準[S]
[6]季君暉史維明,抗菌材料[M]北京,化學(xué)工業(yè)出版社,2003:1-2
[7]王建平,抗菌纖維與抗菌劑體系(二)[J]合成纖維,2003,(3):5-9
[8]江天,有機抗菌防霉劑在抗菌纖維開發(fā)中的應(yīng)用[J]紡織科學(xué)研究,2003,(3):7-18
[9]沈一丁朱平 辛中印等,輕化工助劑[M]北京,中國輕工業(yè)出版社,2004
[10]葛睫王軍 徐虹,抗菌纖維的最新研究進展[J]紡織導(dǎo)報,2006,(3):50-59
[11] American Association Textile Chemical Color Technical Manual.AATCC Test Method 90 [S]55;300-301.
[12]姜文俠,對抗菌防臭纖維制品抗菌效力評價方法的評論[J]紡織學(xué)報,1999,20(2):127-129
[13] American Association Textile Chemical Color Technical Manual.AATCC Test Method 100[S]55;304-306.
[14]王俊起王友斌 鄒海清等,抗菌織物測試方法的研究(續(xù))[J]紡織標準與質(zhì)量,2003,(1);26-28
[15]孟春麗,紡織品的抗菌防臭整理技術(shù)[J]河南紡織高等專科學(xué)校學(xué)報,2004,16(3):61-64
[16]纖維制品衛(wèi)生加工協(xié)議會編:Shake Flask法[S]纖維制品衛(wèi)生加工協(xié)議會,1985;1-5
[17]李雪蓮,抗菌及抗菌防臭纖維的研究(續(xù))[J]上海絲綢,2005,(4):1-13
[l8]吳雄英,1999年AATCC測試標準的變化簡介[J]印染,2000,(5):42-44
[19]JIS Z2911-1992抵抗性試驗方法[S]
來源:中華紡織網(wǎng)

